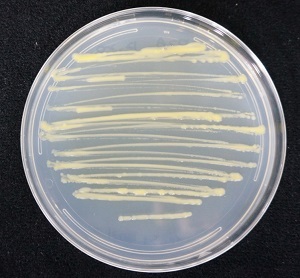

농촌진흥청이 세계 최초로 여러 종류의 살충제를 분해하는 미생물을 발견했다.
농촌진흥청(청장 김경규)은 14일 유기인계 살충제 7종을 분해할 수 있는 미생물 ‘스핑고비움 Cam5-1’ 균주를 토양에서 발견했다고 밝혔다.
7종의 살충제는 국내에서 사용 중인 에토프로포스와 카두사포스, 펜토에이트, 포레이트, 포스티아제이트, 프로페노포스 등 6종과 현재 사용하지 않는 말라티온 등 1종이다.
유기인계 살충제는 세계적으로 가장 많이 사용되는 살충제로 100종 이상이 상용화돼 있으며, 2016년 기준 살충제 시장에서 44%를 차지하고 있다.
유기인계 살충제는 현재 사용 금지된 DDT 등 유기염소계 살충제에 비해 독성과 잔류성은 낮으나 오·남용할 경우 작물과 토양에서 검출될 수 있다.
농진청은 살충제에 스핑고비움 Cam5-1 균주를 처리한 결과, 살충제 종류에 따라 빠르게는 1시간에서 길게는 196시간 이내에 63∼100%가 분해됐다고 설명했다.
또 이 균주를 살충제 카두사포스가 남아 있는 토양에 접종했을 때 2일 만에 살충제가 완전 분해됐고 균주를 접종하지 않은 토양에서는 살충제가 분해되는데 30일 이상 걸렸다.
세계적으로 1종의 살충제를 분해하는 미생물은 알려져 있으나 여러 종의 살충제를 모두 분해하는 경우는 이번에 발견된 스핑고비움 Cam5-1 균주가 처음이다.
저작권자 © 전북일보 인터넷신문 무단전재 및 재배포 금지
개의 댓글
※ 아래 경우에는 고지 없이 삭제하겠습니다.
·음란 및 청소년 유해 정보 ·개인정보 ·명예훼손 소지가 있는 댓글 ·같은(또는 일부만 다르게 쓴) 글 2회 이상의 댓글 · 차별(비하)하는 단어를 사용하거나 내용의 댓글 ·기타 관련 법률 및 법령에 어긋나는 댓글






